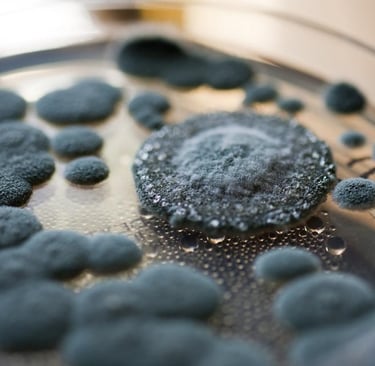

Discovering Mould Types in Canada
We explore the various types of mould found in Canada, providing insights into their characteristics, potential health impacts, and how to identify them in your environment.


Understanding Mould Diversity
Mould Identification and Safety
Our mission is to educate Canadians about mould types, ensuring awareness and safety. We aim to empower individuals with knowledge to recognize and address mould issues effectively.
Moulds are microorganisms that can grow on virtually any substance, indoor and outdoor, as long as moisture, oxygen, and an organic source are present. In nature, moulds play an important role in breaking down organic matter, like fallen leaves, plants and dead animals. But in our workplaces, moulds can be a significant health hazard.
There are over 100,000 mould species in the world, and about 1,000 species commonly found in Canada.
How do moulds affect the health of workers?
Moulds produce thousands of tiny particles called spores as part of their reproductive cycle. When disturbed by air movement or contact, moulds release these spores into the air. The inhalation of spores, moulds or mould fragments can affect your health or make certain health conditions worse.
Lack of moisture causes moulds to become dormant. Dormant moulds still have the capacity to spread spores and fragments into the air and can become active again when moisture returns.
Some moulds create and release mycotoxins, which slowly wear down the immune system and can lead to allergic or respiratory problems. Workers exposed to mould can have different symptoms. Some may have no reaction at all. The most common effects of mould exposure are:
Irritation to the skin, eyes, nose, throat
Burning in the nose, nosebleeds
Difficulty breathing, asthmatic attacks
Watery eyes and runny nose
Nausea
Headaches
Fatigue
difficulty concentrating
Impairment of the immune system
In some cases, lung and liver cancer can result from long-term exposure to aflatoxin, a toxic compound produced by certain moulds.
People with weakened immune systems are particularly susceptible to mould-related illnesses and should avoid being exposed to it whenever possible.
How are mould hazards identified?
A moulds hazard survey can be done in cooperation with the employer, but the union should approve the survey and be involved in collecting and assessing the information. If the employer resists the idea or denies the existence of mould, the union should conduct its own hazard survey.
Visual inspections are the most reliable method of identifying mould problems. When conducting a visual inspection, look for signs of water damage such as discoloration and staining. Be sure to inspect:
carpeting and floor covers
fabric on and underneath furniture
ceiling tiles and drywall
behind furniture
areas where there is standing water, like sinks, kitchens, air conditioners, etc.
Moulds can appear as dark spots or patches of any colour. They can have a variety of textures from woolly to slimy. They thrive in dark, moist environments, so they may be hidden from view. Dormant moulds often have a dry, powdery or crusty appearance.
Air sampling, surface sampling and bulk sampling (taking bits of drywall, flooring, etc.) are also used to identify moulds. The person taking samples must be properly trained and wear appropriate personal protective equipment.
How to prevent moulds from forming in your workplace
It is your employer’s responsibility to provide you with a healthy and safe workplace. Part of this duty is to ensure that all workers are protected from the health risks of mould. Mould hazards often arise as a result of cutbacks or employer neglect.
The following can help prevent mould growth in your workplace:
Keep relative humidity in the workplace between 30 and 60 per cent.
Conduct regular inspections and be diligent, particularly if you work in a sewage treatment plant or composting facility.
Make sure landscaping and eaves trough downspouts direct water away from buildings.
Ensure any high moisture areas are properly ventilated with local exhaust ventilation that captures the moisture and directs it out of the building.
Get the employer to insulate cold surfaces to prevent condensation on pipes, windows, walls, roofs and floors.
Perform regular maintenance and cleaning of heating, ventilation and air conditioning systems.
Perform regular maintenance of buildings, especially roofs, basements and other locations where there are leaks.
Ensure proper staffing to conduct maintenance procedures, such as fixing and maintaining plumbing systems and fixing building leaks to prevent mould growth and other workplace hazards.
Most Canadian jurisdictions have a “general duty provision” in their occupational health and safety legislation requiring employers to take all reasonable precautions to protect the health and safety of employees, which includes protecting them from mould hazards. PSAC recommends that members negotiate contract language for specific controls, monitoring and access to information about moulds.
What should you do if there is mould in your workplace?
If you discover mould in your workplace, you should report it to management immediately. If the problem is not immediately rectified, report it to your health and safety committee, so that they can assist until the problem is fixed.
Fixing a mould problem includes identifying and correcting the conditions that allow mould to grow and the safe removal of materials damaged by mould. Appropriate personal protective equipment should be used when doing this. The cleaning and removal process depends on the size and type of mould growth, the extent of the damage, and the location.
Trained professionals should work on removing the mould. In workplaces where staff are expected to participate in mould removal, workers must be properly trained in mould remediation and the hazards associated with working around mould. Staff should be provided with appropriate personal protective equipment. If your employer refuses to deal with mould, you may need to exercise your right to refuse work to protect your own health
You didn’t come this far to stop


Contact Us

For inquiries about the types of mould in Canada, please reach out to us anytime.
Types of Moulds
Discover the various types of mould found in Canada and their potential impact on health.
Mold growth in homes is a serious concern that many Ottawa residents may overlook until it becomes a health issue. Mold is not only unsightly but can also have significant effects on the respiratory system. Understanding the connection between mold and respiratory health is crucial for homeowners in Ottawa, where humidity levels and aging homes create ideal conditions for mold growth. In this article, we will explore how mold affects respiratory health and what steps Ottawa homeowners can take to prevent and address mold growth through mold removal in Ottawa.
What is Mold and How Does it Grow in Homes?
Mold is a type of fungus that thrives in damp, humid environments. It reproduces through spores that spread through the air and can settle on surfaces, where they grow when exposed to moisture. Common indoor molds include species such as Aspergillus, Cladosporium, and Stachybotrys (black mold).
Mold requires moisture to grow, which is why it is frequently found in areas of the home where water damage or high humidity is present, such as basements, bathrooms, and attics. In Ottawa, the seasonal fluctuations in temperature and humidity contribute to mold growth, particularly in older homes that may have structural issues like leaks or poor insulation. It’s important for homeowners to recognize the conditions that promote mold and take steps to mitigate the risks.
The Respiratory Health Risks of Mold Exposure
Mold exposure is linked to several respiratory health problems. The most common issues include allergic reactions, asthma, chronic coughing, and sinus congestion. Mold spores, when inhaled, can trigger these conditions, especially in sensitive individuals. People with asthma or respiratory diseases are at a higher risk of experiencing exacerbated symptoms, which can lead to more severe health issues over time.
For Ottawa residents, the humid summers and cold winters can create the perfect breeding ground for mold, especially in homes that have had water damage due to flooding or condensation. Even if the mold is not visibly present, its spores can still be in the air, causing respiratory distress in those who are exposed to it regularly.
Mold Growth in Ottawa Homes: Specific Concerns
Ottawa’s climate presents unique challenges for homeowners trying to avoid mold growth. During the humid summer months, moisture can accumulate in the home, and without proper ventilation, mold can start to grow. In winter, the cold air outside can lead to condensation on walls and windows, creating the perfect environment for mold to thrive.
Older homes in Ottawa are particularly susceptible to mold growth due to outdated insulation, poor ventilation, and the likelihood of hidden leaks in the plumbing. Homeowners who experience basement flooding, roof leaks, or faulty windows should be especially diligent about monitoring for mold growth and taking preventive measures.
Identifying Mold-Related Health Symptoms
If you suspect that mold might be affecting your home, it’s essential to watch for signs of respiratory issues, especially in family members who may be particularly sensitive. Common symptoms of mold exposure include:
Persistent coughing or wheezing
Nasal congestion or a runny nose
Sneezing, especially in the morning
Irritation of the throat, eyes, or skin
Fatigue and general malaise
Press enter or click to view image in full size
For Ottawa homeowners, recognizing these symptoms early can prevent further complications. If anyone in your household is experiencing these issues and you suspect mold may be the culprit, seeking mold removal in Ottawa should be a priority. Early intervention can help mitigate health risks and protect the home’s occupants from ongoing exposure.
Mold Prevention and Remediation in Ottawa Homes
Preventing mold growth in Ottawa homes is possible with proper maintenance and attention to moisture control. Key steps to prevent mold include:
Control Humidity Levels: Keep indoor humidity levels below 60%. This can be achieved using dehumidifiers, especially in areas like basements or bathrooms.
Improve Ventilation: Proper ventilation is essential in areas prone to moisture, such as bathrooms and kitchens. Ensure that vents lead outdoors, not into attics or crawl spaces.
Fix Leaks Quickly: Water leaks are the most common way mold enters a home. Whether it’s a leaking pipe, a roof leak, or condensation around windows, repairing leaks as soon as they occur can help prevent mold from taking hold
Routine Inspections: Regularly check areas where mold is more likely to grow, such as the basement, attic, and behind appliances. If you spot early signs of mold growth, act immediately by calling in a professional for mold removal in Ottawa.
If mold has already taken hold in your home, it’s important to enlist the help of professional mold remediation services. Mold removal in Ottawa involves specialized equipment and techniques to ensure that the mold is fully removed, and the underlying moisture problems are addressed. Trying to remove mold yourself can sometimes make the issue worse, as mold spores can spread if not properly contained.
Protect Your Health: The Importance of Mold Removal in Ottawa Homes
If you suspect mold is affecting your home, taking action is crucial not only for the well-being of your property but also for the health of your family. Mold removal in Ottawa is essential for eliminating mold-related health risks and improving indoor air quality. Professional remediation services can safely remove the mold, identify the source of moisture, and provide recommendations for keeping your home mold-free.
Take Action Today
Don’t wait until mold affects your health. If you suspect mold in your home, contact a professional mold removal company in Ottawa right away. By addressing mold issues early, you can prevent respiratory health problems and ensure that your home remains a safe, healthy place for you and your family.
Press enter or click to view image in full size
If you live in Ottawa and are concerned about mold in your home, make sure to schedule an inspection with a trusted mold removal in Ottawa expert. Protect your home and your health by taking the necessary steps today.
ottawa mould
Contact
Support
mould
© 2024. All rights reserved.